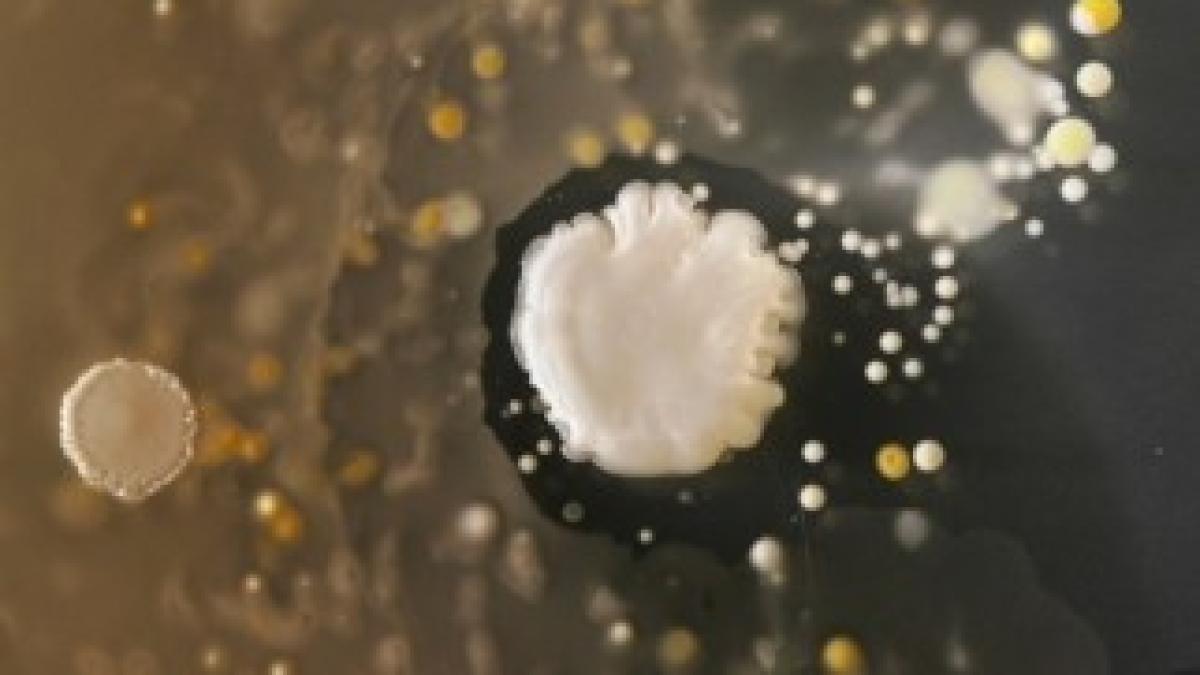
84

€ 5.2364 →
|
$ 4.4493 →
|
Fiți la curent cu ultimele noutăți. Urmăriți DCNews și pe Google News





























































































 Moțiunea de cenzură se joacă până la ultimul vot: aici pot apărea surprize. Două scenarii care nu sunt excluse
Moțiunea de cenzură se joacă până la ultimul vot: aici pot apărea surprize. Două scenarii care nu sunt excluse
de Val Vâlcu